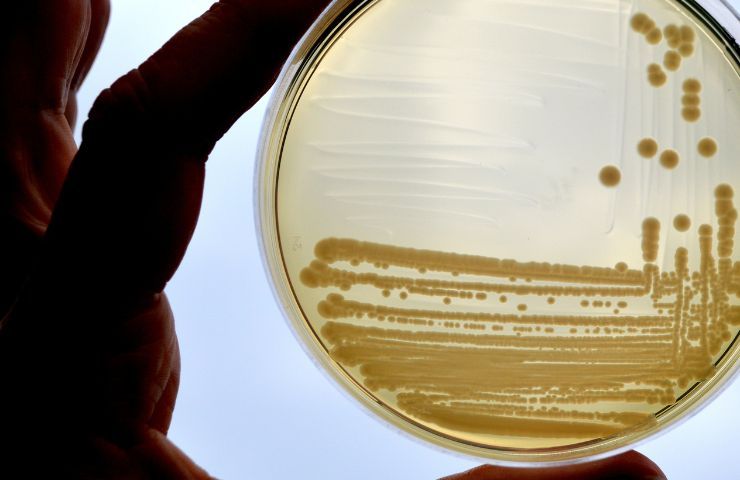

Cosa sai dell’elettricità e delle acque reflue? Le prestazioni migliorano enormemente grazie all’Escherichia coli. Tutti i dettagli.

Se si pensa all’energia viene in mente immediatamente l’elettricità. Si tratta di un’energia causata dallo spostamento degli elettroni e maggiore sarà la loro velocità , maggiore sarà l’energia elettrica da loro trasportata.
Oggi l’elettricità viene utilizzata per qualsiasi cosa, a partire dall’illuminazione, passando dal funzionamento degli elettrodomestici e per finire con le innovative auto elettriche. Ma come si ottiene l’elettricità? Oggi sappiamo che è possibile ottenerla tramite fonti di energia rinnovabile come il fotovoltaico o l’eolico, ma è bene sapere che questa fonte di energia è ottenibile anche grazie all’acqua.
Ad esempio, è possibile ottenere elettricità sfruttando l’acqua degli oceani. Tuttavia, non è la sola acqua capace di produrla. Di recente si è scoperto che persino le acque reflue possono essere utilizzate per la produzione di energia elettrica ed in più sembra che l’escherichia coli riesca a migliorare questa produzione.
Il ruolo dell’escherichia coli nella produzione di elettricità dalle acqua reflue

Uno studio condotto da un team di ricercatori dell’Ecole Polytechnique Federale de Lausanne ha mostrato come sia possibile migliorare la capacità batterica dell’escherichia coli di generare elettricità. E’ risaputo che batteri come l’Escherichia coli non siano grandi produttori di energia a causa della loro scarsa capacità di trasferire elettroni extracellulari, una capacità resa attuabile grazie alle molecole esogene presenti nell’ambiente che fanno da mediatrici.
Questa capacità batterica viene utilizzata già oggi nell’ambito delle biotecnologie, ma ci sono comunque delle sfide da superare per ottimizzare la produzione energetica. Una delle maggiori sfide ce la ricorda il professor Artemis Boghossian dell’Ecole Polytechnique Federale de Lausanne.
La maggior parte dei microbi esotici può produrre energia elettrica solo in presenza di alcune specifiche sostanze chimiche. L’escherichia coli, però, può crescere in diversi ambienti, senza aver bisogno di determinate sostanze chimiche e questo fa si che si possano sfruttare le acque reflue come ambiente. La vera innovazione, però, è stata messa a punto dal team di ricerca poiché gli scienziati sono riusciti a modificare l’escherichia coli migliorando il trasferimento di elettroni extracellulari.
Per far sì che il risultato fosse possibile il team di ricerca ha realizzato un percorso di trasferimento elettronico dell’Escherichia coli, inserendo anche dei componenti di Shewanella oneidensis MR-1.
In questo modo la corrente generata dall’escherichia coli presente nelle acque reflue è aumentata di 3 volte. Sono stati quindi effettuati diversi test in diversi ambienti, tra cui anche le acque reflue di un birrificio di Losanna. I possibili effetti di questo studio sono stati pubblicati sul magazine Cell.






